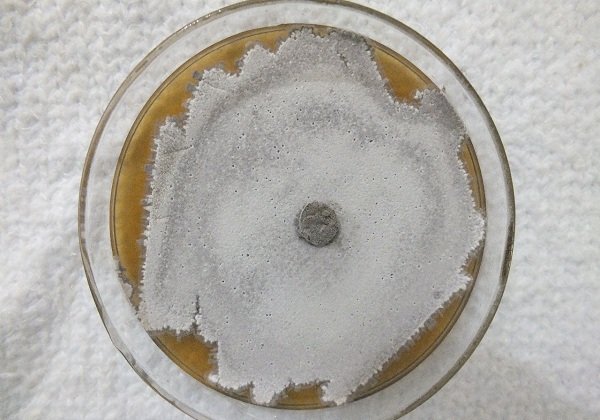

As fortes chuvas que caem em todo estado desde o final da última semana já causaram situação de emergência em pelo menos cinco cidades baianas. As prefeituras de Itaquara, Jaguaquara, Maragogipe, Ruy Barbosa e Mairinque, no interior baiano, já decretaram situação de emergência em razão dos estragos provocados pela água. As três primeiras já tiveram o estado reconhecido pelo governo federal, o que possibilita uma assistência emergencial prestada pela União.
Em Maragogipe, uma das cidades mais atingidas, as chuvas foram fortes nas madrugadas de sábado (06) e domingo (07). Por lá, a água fez um rio transbordar e cerca de 30 famílias tiveram as casas invadidas pela força da chuva, tendo que se abrigar em uma pousada localizada em uma área mais alta da cidade. Há três dias os moradores estão sem energia elétrica e as aulas na rede escolar foram suspensas, com previsão de retorno apenas para o dia 11, na modalidade remota.